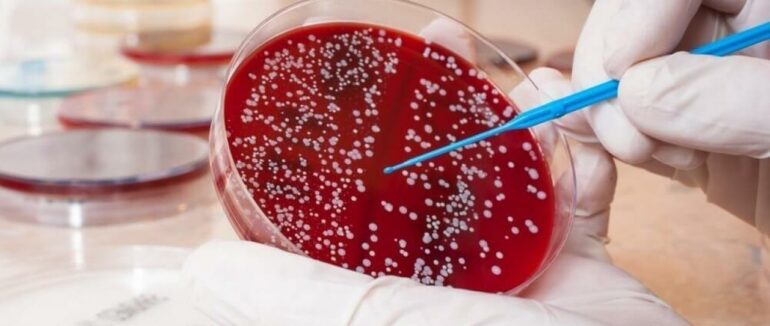
На Закарпатті у 28 працівників їдалень  освіти виявили стафілококом

У 28 працівників харчоблоків закладів освіти Закарпаття виявили золотистий стафілокок. Це 5,6 % від загальної кількості протестованих, — повідомляє Cуспільне з посиланням на заступницю генерального директора Закарпатського обласного центру контролю та профілактики хвороб Тетяну Літовченко
За її словами, станом на 21 жовтня на Закарпатті 15 випадків виявили у дошкільних закладах, 12 — у закладах середньої освіти та один у інтернаті. Випадки стафілококу зареєстрували в Ужгороді, Мукачеві, Сваляві, Іршаві, Виноградові та Перечині.
Раптові перевірки представники центру контролю та профілактики хвороб провели у 179 навчальних закладах. Обстежили 102 заклади дошкільної освіти, 72 заклади загальної середньої освіти та 5 інтернатних закладів.
"Станом на 21 жовтня на Закарпатті перевірили 496 працівників харчоблоків: 260 працівників ДНЗ, 214 — закладів середньої освіти та 22 працівників інтернатів. Стафілокок виявили у 28 працівників харчоблоків. Результати ще 56 аналізів наразі очікують", — розповіла Тетяна Літовченко.
Ззначимо, що Золотистий стафілокок одна з бактерій, які відносять до антибіотикорезистентних. Тобто штами золотистого стафілокока стійкі до лікування антибіотиками. Золотистий стафілокок потрапив до переліку ВООЗ найбільш небезпечних для людини бактерії саме через антибіотикорезистентність.